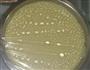
香蕉冰激凌的做法图解16

| 香蕉冰激凌热量分析 (可根据实际输入食材份量计算。数据仅供参考) | |||||
|---|---|---|---|---|---|
| 食材名称 | 食材份量 | 热量 | 标准度量(每100克) | 蛋白质 | 脂肪 |
| 牛奶 | 克 | 47千卡 | 42千卡 | 6.81克 | 3.2克 |
| 香蕉 | 克 | 158千卡 | 89千卡 | 1.09克 | 0.33克 |
| 总量 | 290克 | 香蕉冰激凌热量/卡路里205千卡 | |||
香蕉冰激凌的做法共19个步骤
食材主料/辅料
牛奶(2袋)、香蕉(2根)、淡奶油(适量)、淀粉(2大勺左右)、鸡蛋(4个)、白糖(适量)

1/19. 牛奶2袋(几个人吃就放几袋牛奶)。

2/19. 将牛奶放入豆浆机。

3/19. 香蕉切成小块,也放入豆浆机,同时放入淀粉。(有几袋牛奶,就放几个香蕉。)

4/19. 选择果汁键搅拌。

5/19. 搅拌好的牛奶、香蕉混合液。如果有淀粉块,就自己拿筷子再搅拌一下。

6/19. 将混合液倒入锅中备用。

7/19. 鸡蛋4个。(一袋牛奶配2个鸡蛋。)

8/19. 将蛋黄取出,蛋清不要。

9/19. 将鸡蛋黄快速搅拌5分钟。(没有打蛋器的同学,用一把筷子打鸡蛋,效果是一样滴!)

10/19. 打好的蛋黄液。

11/19. 锅中放白糖,根据自己喜好添加。

12/19. 小火将混合液烧到起小泡,然后用最低的火,一手快速搅拌,一手一点一点的把蛋黄液倒进去,一定要慢!切记!一次只能倒一点点。鸡蛋液倒完后,放入奶油,可根据自己喜好添加。

13/19. 锅中再次起小泡,关火。

14/19. 倒入碗中晾凉。

15/19. 晾凉后盖上保鲜膜、或盖子。放入冰箱冷冻室。
16/19. 每隔2-3个小时拿出来搅拌一次,一般来说拿出来搅拌两次后,就不用再搅拌了。

17/19. 奥利奥饼干,去掉里面的奶油,只要外面的硬饼干,装入保鲜袋。

18/19. 用擀面杖压碎。

19/19. 盛一大勺冰激凌在碗里,然后撒上一些饼干碎,就可以吃咯!
食材功效信息
牛奶的热量42千卡(每100克);有利含量:低钠盐,低饱和脂肪酸,富含钾;具有美容、防治近视、美容养颜等功效;可与甘蔗、黑豆、木瓜搭配;与米汤、醋、果汁相克,同食可能会引起不适;
香蕉的热量89千卡(每100克);有利含量:低胆固醇,低钠盐,低饱和脂肪酸;具有降血压、预防便秘、益胃生津等功效;可与芝麻、牛奶、燕麦搭配;与土豆、芋头、酸奶相克,同食可能会引起不适;
你可能还喜欢
营养信息
- 香蕉冰激凌热量205 千卡
- 脂肪3.53 克
- 蛋白质7.9 克
- 碳水化合物26.24 克
- 钠38.2 毫克
- 钙266 毫克
- 铁0.29 毫克
- 钾467 毫克










